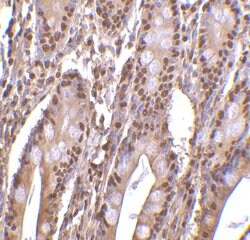
PHAP III Polyclonal Antibody 100 &mu;g | Buy Online | Invitrogen | Fisher Scientific

missing translation for 'onlineSavingsMsg'
Learn More
Learn More
PHAP III Polyclonal Antibody


Description
PHAP III Polyclonal Antibody for Western Blot, IHC

Specifications
Specifications
| Antigen | PHAP III |
| Applications | Immunohistochemistry, Western Blot, Immunocytochemistry |
| Classification | Polyclonal |
| Concentration | 1 mg/mL |
| Conjugate | Unconjugated |
| Formulation | PBS with 0.02% sodium azide |
| Gene | ANP32A |
| Gene Accession No. | O35381, P39687, P49911 |
| Gene Alias | 2810018A15Rik; Acid nuclear phosphoprotein 32 (leucine rich); acidic (leucine-rich) nuclear phosphoprotein 32 family, member A; acidic (leucine-rich) nuclear phosphoprotein 32 family, member E; acidic leucine-rich nuclear phosphoprotein 32 family member A; Acidic leucine-rich nuclear phosphoprotein 32 family member E; Acidic leucine-rich nuclear phosphoprotein 32 family member E-like protein; acidic nuclear phosphoprotein 32; acidic nuclear phosphoprotein 32 family member A; acidic nuclear phosphoprotein 32 family member E; acidic nuclear phosphoprotein 32 family, member A; acidic nuclear phosphoprotein pp32; AI047746; AI326868; Anp32; Anp32a; Anp32e; C15orf1; cerebellar leucine rich acidic nuclear protein; cerebellar postnatal development protein 1; Cpd1; hepatopoietin Cn; HPPCn; I1PP2A; inhibitor-1 of protein phosphatase-2A; LANP; LANPL; LANP-L; LANP-like protein; Leucine-rich acidic nuclear protein; leucine-rich acidic nuclear protein LANP; leucine-rich acidic nuclear protein like; MAPM; Mapmodulin; mLANP-L; PHAP1; PHAPI; Potent heat-stable protein phosphatase 2A inhibitor I1PP2A; pp32; Putative HLA-DR-associated protein I; putative human HLA class II associated protein I; RP4-790G17.1; vacidic (leucine-rich) nuclear phosphoprotein 32 family, member A; W91701; wu:fb22e03; wu:fc04c12; wu:fc19a08; wu:fc79f04; wu:fi39c10; zgc:65995; zgc:85827 |
| Gene Symbols | ANP32A |
| Show More |
Product Title
By clicking Submit, you acknowledge that you may be contacted by Fisher Scientific in regards to the feedback you have provided in this form. We will not share your information for any other purposes. All contact information provided shall also be maintained in accordance with our Privacy Policy.
Spot an opportunity for improvement?